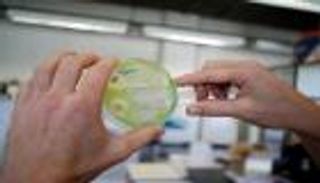
حل لغز انتشار بكتيريا المضادات الحيوية في أوروبا

إنفوجراف.. الأسبوع العالمي للتوعية بالمضادات الحيوية

إنفوجراف يوضح أبرز المعلومات عن الأسبوع العالمي للتوعية بخطورة المضادات الحيوية الذي تحييه منظمة الصحة العالمية وشركاؤها
تحيي منظمة الصحة العالمية وشركاؤها الأسبوع العالمي للتوعية بخطورة المضادات الحيوية، خلال الفترة من 18 إلى 24 نوفمبر/تشرين الثاني، تحت شعار "مستقبل المضادات الحيوية مرهون بنا جميعا".
ويهدف إحياء الأسبوع العالمي لزيادة الوعي بمقاومة المضادات الحيوية، والتشجيع على اتباع أفضل الممارسات فيما بين صفوف عامة الجمهور والعاملين الصحيين.
وأعلنت المنظمة العالمية أن البكتيريا المقاومة للمضادات الحيوية قد ينجم عنها وفاة ملايين الأشخاص، متوقعة أن تكلف أنظمة الرعاية الصحية حول العالم مليارات الدولارات بحلول عام 2050.
وأظهر النظام العالمي لمراقبة مقاومة مضادات الميكروبات "جلاس" (GLASS) انتشار مقاومة المضادات الحيوية على نطاق واسع بين نصف مليون شخص، ممن يشتبه بإصابتهم بالتهابات بكتيرية في 22 بلدا.
الإنفوجراف التالي يوضح أبرز المعلومات عن الأسبوع العالمي للتوعية بخطورة المضادات الحيوية.